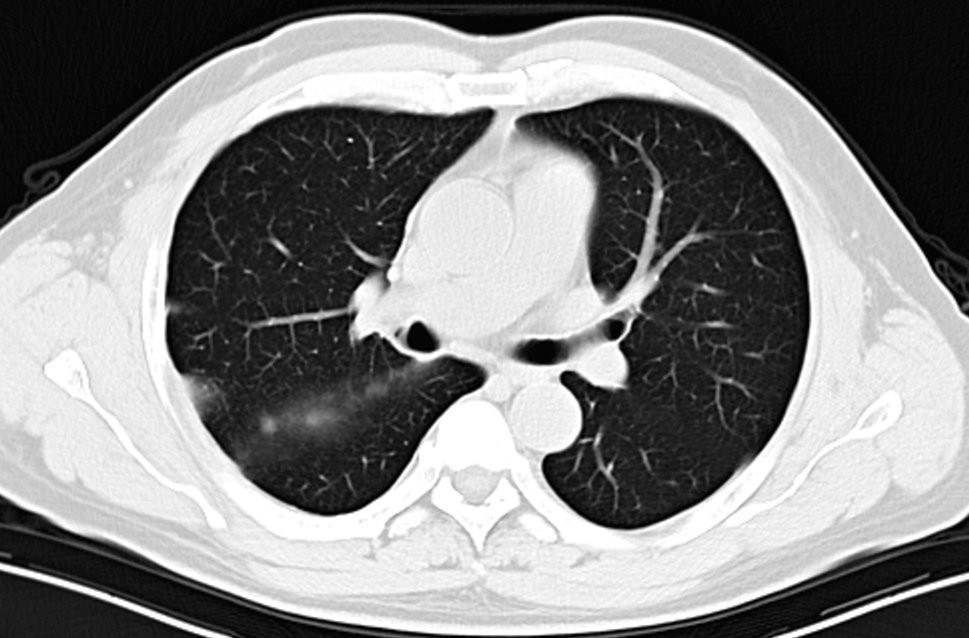
海南首例恶性胸膜间皮瘤,胸膜间皮瘤生存5年算治愈吗
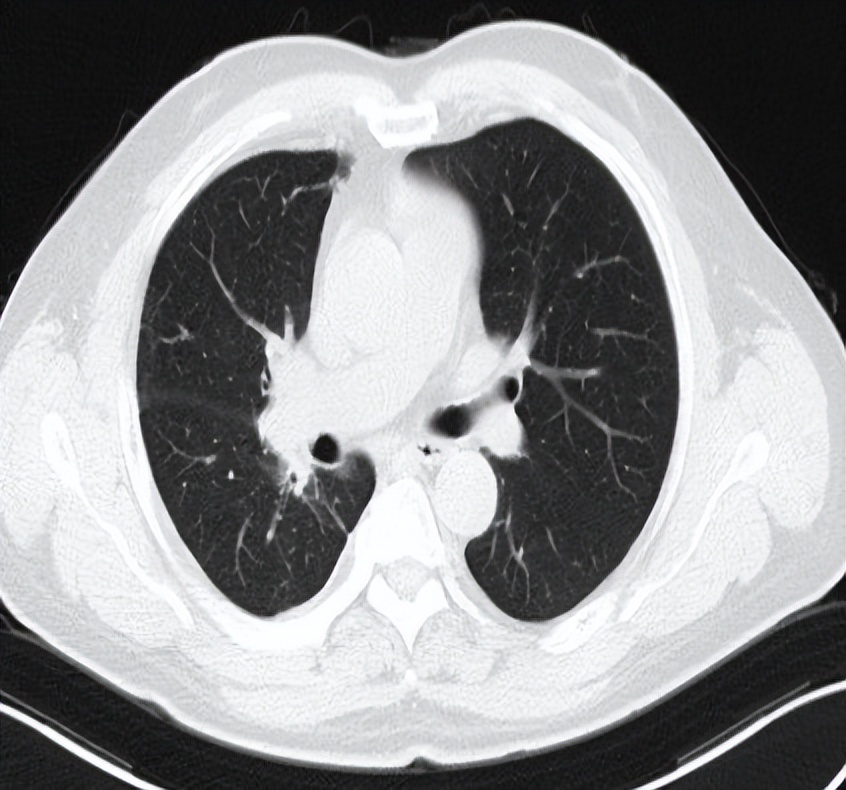
海南首例恶性胸膜间皮瘤,胸膜间皮瘤生存5年算治愈吗

胸膜间皮瘤(pleural mesothelioma) 是一种来源于胸膜间皮细胞的原发肿瘤,占胸膜肿瘤的5%,侵袭性高的恶性肿瘤。临床表现与侵袭行为有关,它通常局部侵袭胸膜腔及周围结构。如果不积极治疗,中位生存期4~12个月。
患者男性,56岁,因反复咳嗽入院 2016.12.22行胸部CT检查提示:右侧胸膜为广泛增厚呈不规则状、结节样的增厚,右侧胸腔可见有大量的胸腔积液。纵隔、肺门淋巴结不大,考虑胸膜间皮瘤可能。于2017-1-10行VATS右胸膜活检术,术后病理提示(右胸膜)恶性肿瘤,结合酶标结果考虑恶性间皮瘤。免疫组化结果:TTF-1(-),NapsinA(-),CK7(+),WT-1(+),CK5/6(+),CAL(+),MC(+),D2-40(+)。术后恢复良好,术后予抗炎、补液等对症治疗,诊断为:右侧胸膜间皮瘤cT4N1M0-IIIB期。患者于2017-2至2017-5行AP(培美曲赛联合顺铂)方案化疗共4周期。2017-6-27胸部CT检查提示疗效部分缩小(PR)。




考虑到胸膜间皮瘤当时并没有维持治疗的临床研究结果,借鉴非小细胞肺癌维持治疗的研究数据,给予培美曲赛维持化疗,共25周期。

患者2020.6.16入院完善相关检查,评估疗效PD,考虑到二线化疗推荐吉西他滨,既往联合铂类也获得了不错的疗效,于2020-6-18至2020-9-21行二线化疗GP(吉西他滨1.8gD1、8+奈达铂45mgD1-3)方案化疗共4周期,后于2020-10-21行G-T1(吉西他滨1.8g)单药维持化疗。


2021-5-21日入院后完善相关检查,胸部CT检查提示病灶进展,后予以化疗+抗血管治疗(白蛋白紫杉醇480mgd1+贝伐珠单抗600mg)治疗,并行右侧胸膜SBRT治疗(40Gy/5F),治疗周期为8周期,最佳疗效为PR。






2022-3-6入院复查胸部CT见右肺上叶病灶增大,评价为病情进(PD),予以行胸部SBRT治疗,总剂量40Gy/8Fx。



其实到四线治疗的药物并没有太多选择,免疫治疗推荐:纳武利尤单抗联合伊匹木单抗,考虑到药物的价格及可及性(患者承受不起),患者考虑其他的免疫治疗方法。患者既往使用培美曲赛获得了40个月的PFS,联合免疫可能会有更好的治疗效果。采用立体定向放疗,除了可以更好的控制疾病以外,更多的考虑可以杀死肿瘤细胞,改善肿瘤微环境,释放肿瘤相关抗原,诱导远隔效应的产生。
放疗结束后予以培美曲赛+替雷利珠单抗治疗(培美曲塞0.9g d1+替雷利珠单抗200mg)治疗,现维持治疗至今(2022-8-20)。

胸膜间皮瘤为恶性程度高的胸膜恶性肿瘤,大部分患者在诊断时候已经是晚期,手术效果欠佳。恶性胸膜间皮瘤治疗了经历了吉西他滨、培美曲塞化疗、化疗联合贝伐珠单抗、及纳武利尤联合伊匹木免疫治疗等历程。具体到每个患者的治疗过程也需要根据患者的具体情况及药物可及性来选择合适的治疗药物,适时地加入放射治疗来更好的控制局部进展,使患者得到更好的生存获益。